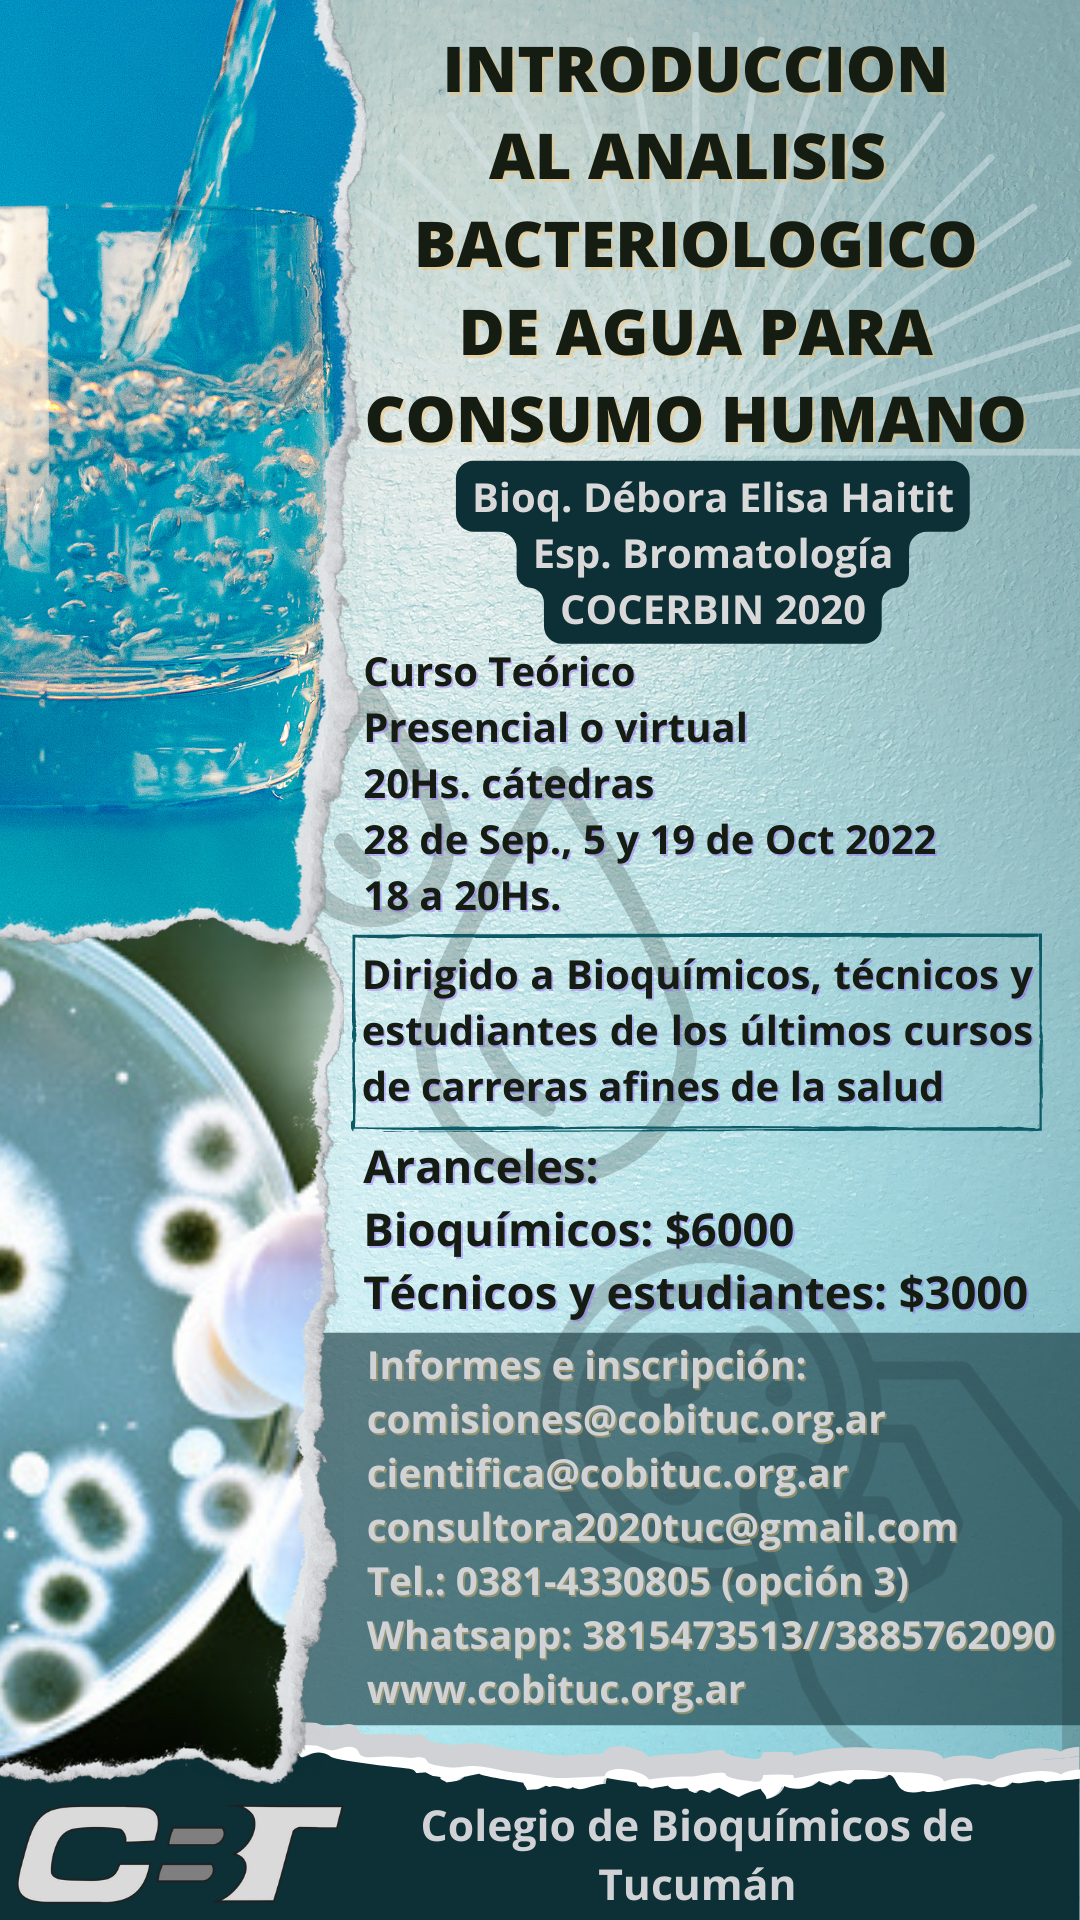
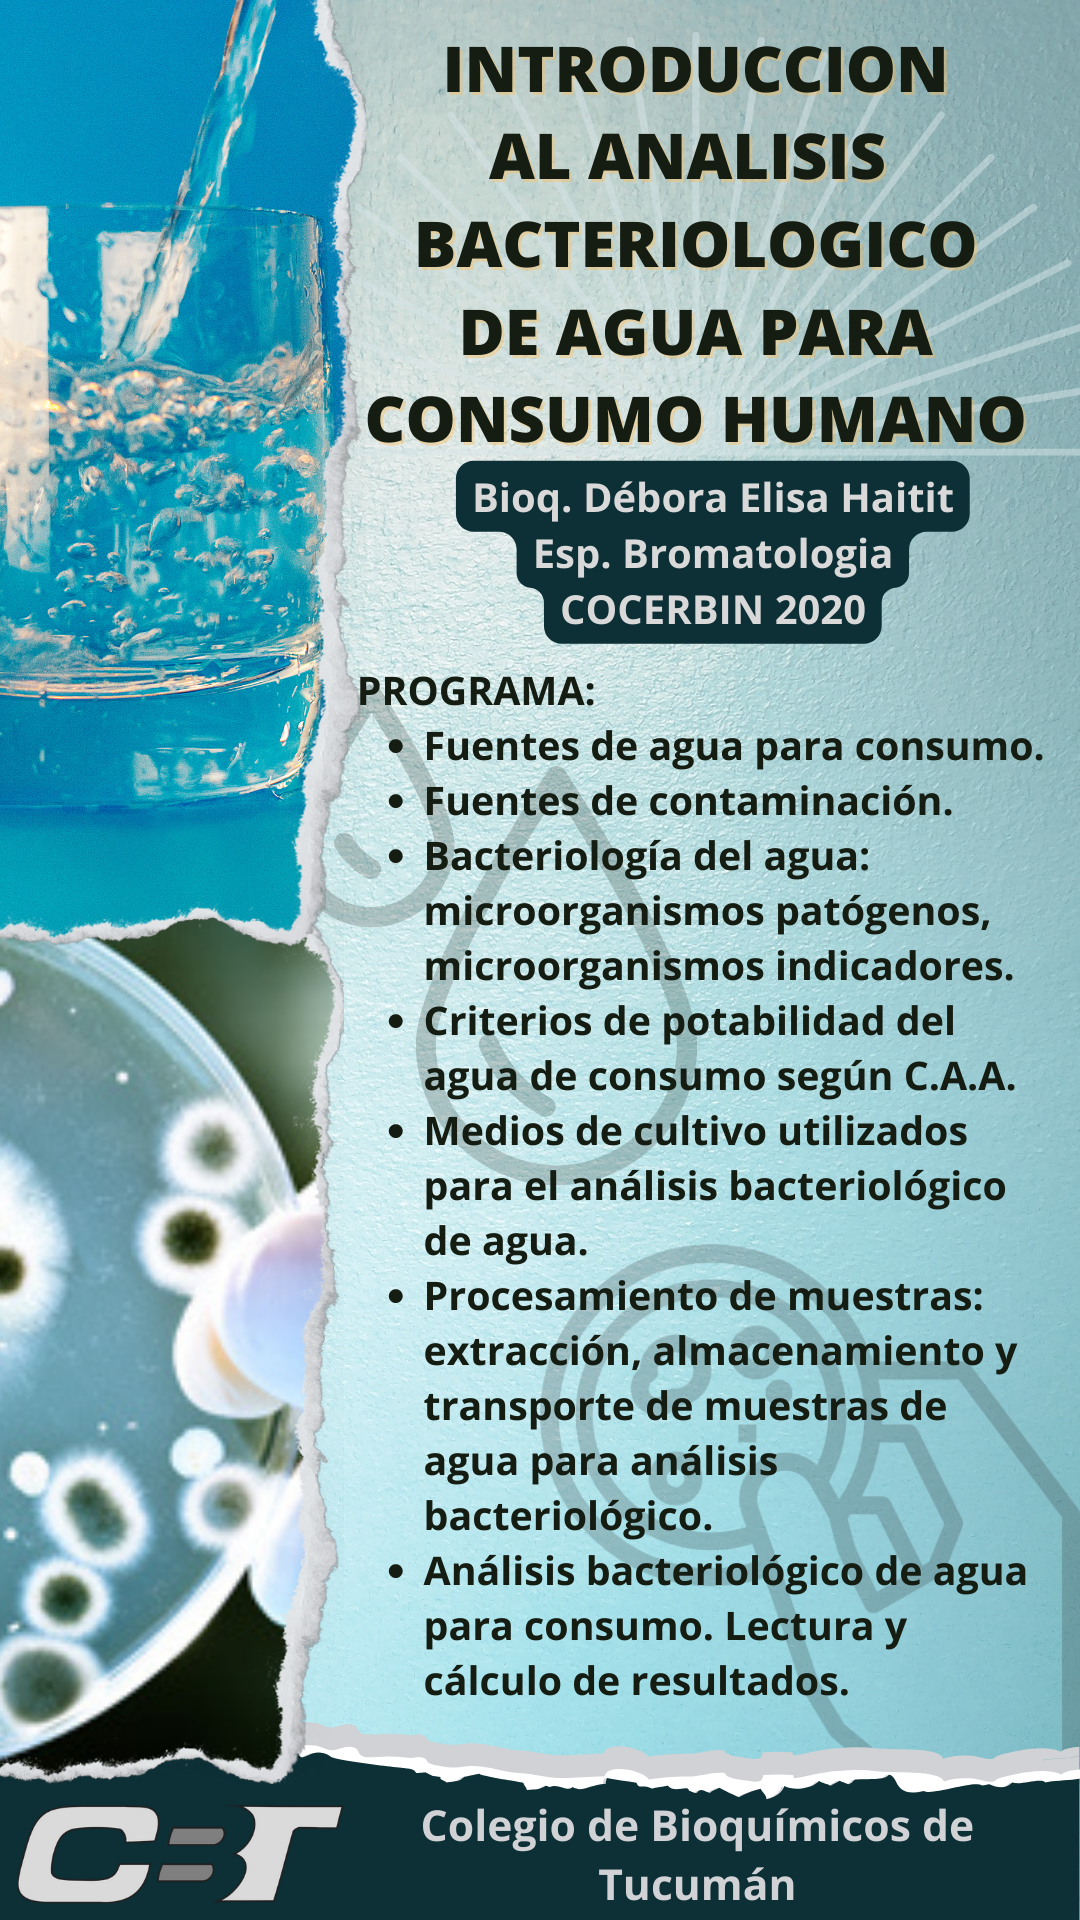
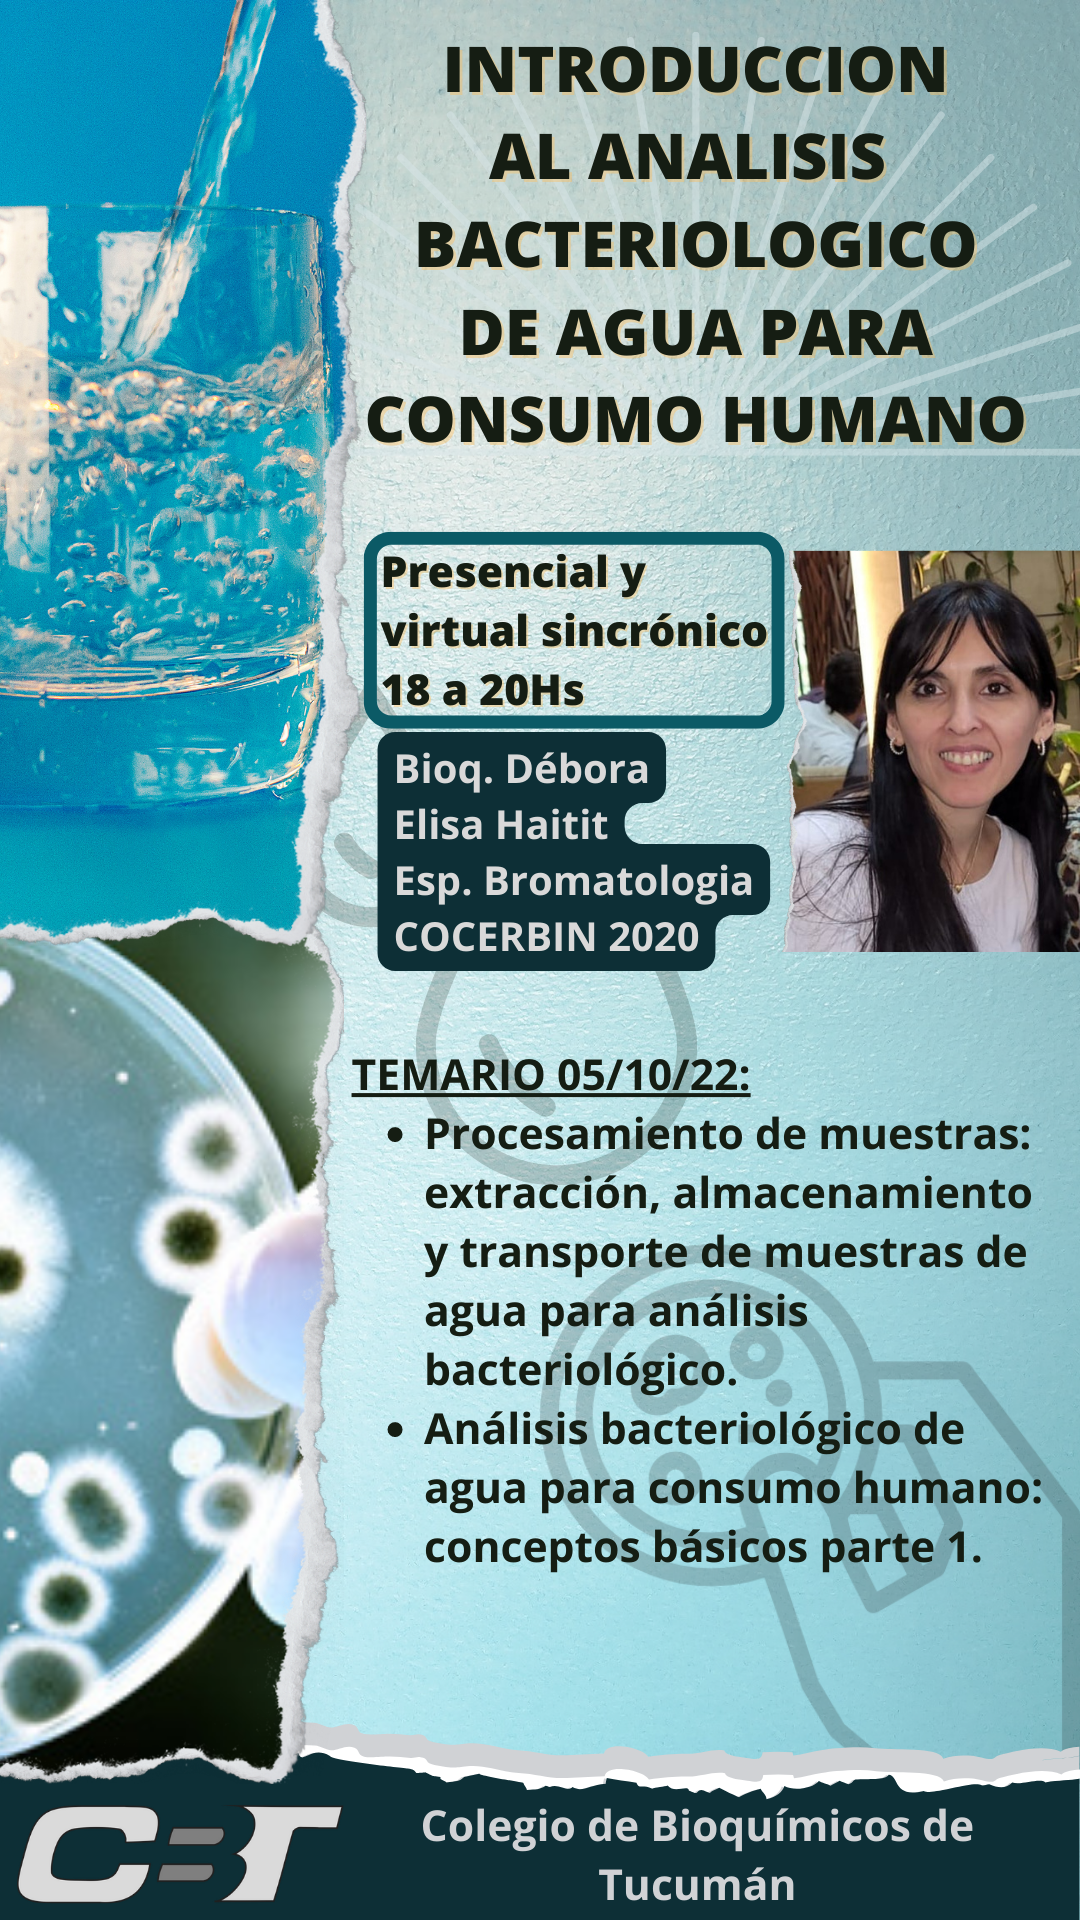
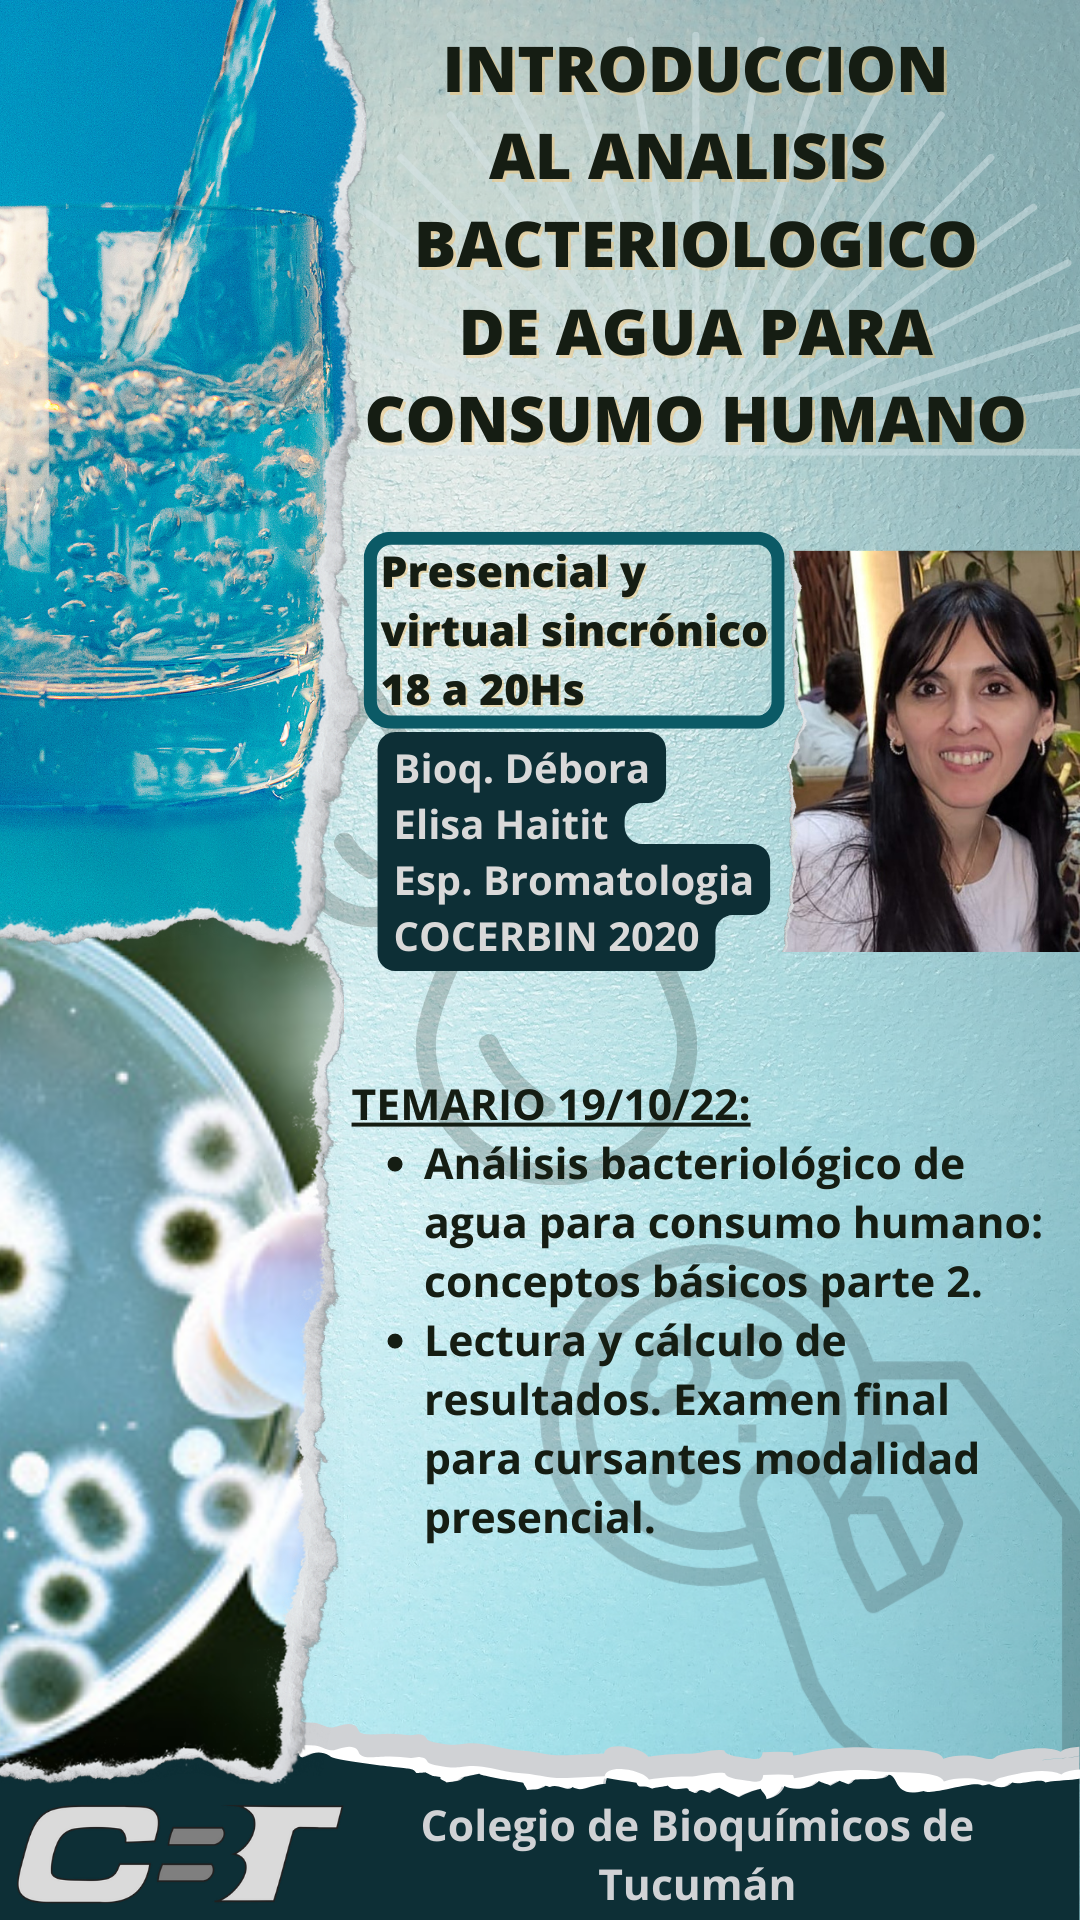

Haga click para completar el formulario de inscripción
Dirección: Av. República del Líbano 978
Teléfono: 0381-4330805
Email: colbioquimicos@cobituc.org.ar
Web: www.cobituc.org.ar
Colegio de Bioquímicos de Tucumán
Diseño: Dpto. Computos
